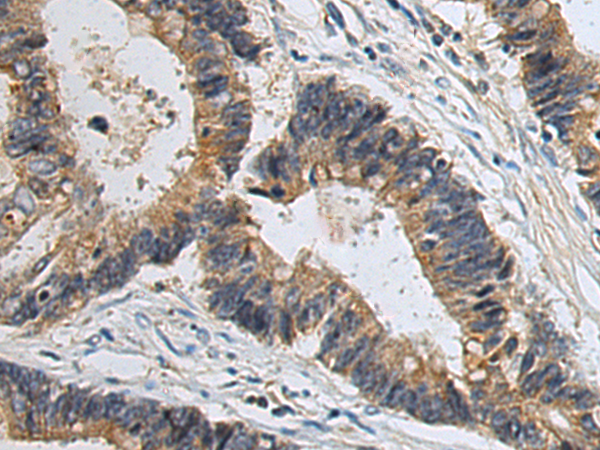

中文名稱: 兔抗SLC22A12多克隆抗體
儲 存: 冷凍(-20℃)
宿 主: Rabbit
抗 原: SLC22A12
克隆類型: rabbit polyclonal
技術規格
Background:
The protein encoded by this gene is a member of the organic anion transporter (OAT) family, and it acts as a urate transporter to regulate urate levels in blood. This protein is an integral membrane protein primarily found in epithelial cells of the proximal tubule of the kidney. An elevated level of serum urate, hyperuricemia, is associated with increased incidences of gout, and mutations in this gene cause renal hypouricemia type 1. Alternative splicing results in multiple transcript variants.
Applications:
ELISA, WB, IHC
Name of antibody:
SLC22A12
Immunogen:
Synthetic peptide of human SLC22A12
Full name:
solute carrier family 22 member 12
Synonyms:
RST; OAT4L; URAT1
SwissProt:
Q96S37
ELISA Recommended dilution:
5000-10000
IHC positive control:
Human cervical cancer and Human colorectal cancer
IHC Recommend dilution:
50-100
WB Predicted band size:
60 kDa
WB Positive control:
293T cell lysate
WB Recommended dilution:
500-2000

購物車
購物車 幫助
幫助
 021-54845833/15800441009
021-54845833/15800441009
